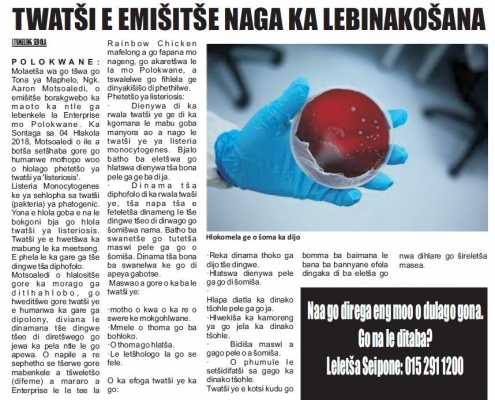

OVERVIEW
The South Africa Agency for Science and Technology Advancement (SAASTA) is a business unit of the National Research Foundation (NRF) with the mandate to advance public awareness, appreciation and engagement of science, engineering, innovation and technology in South Africa. Find out more